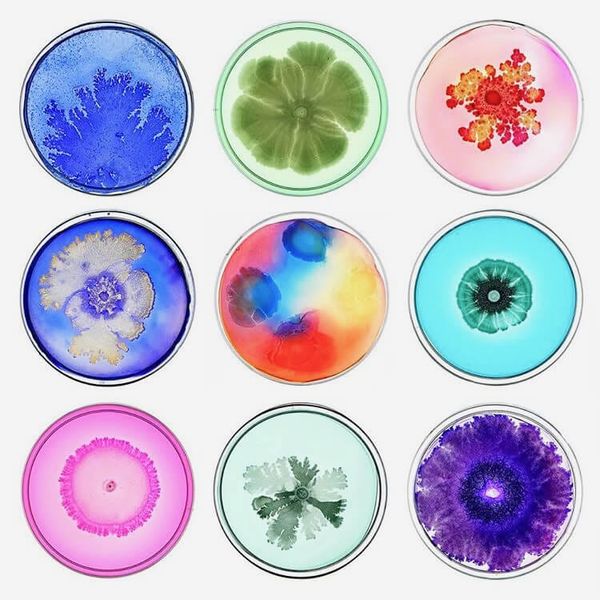
Tal Danino

Wim van Egmond
Mind-blowing microphotography by Wim van Egmond. From the birth of a water-flea, to ciliates eating each other, to a duel between fungi — using a combination of microscopy and stereoscopy, he's able to capture it all.
![]() Wim van Egmond →
Wim van Egmond →


 Bookshop.org →
Bookshop.org →
Tal Danino Art →
Tal Danino Art →

 Designer Shit →
Designer Shit →

 New Atlas →
New Atlas →


 National Institutes of Health →
National Institutes of Health →


 Instagram →
Instagram →

 Huberman Lab →
Huberman Lab →

 Fantastic Fungi →
Fantastic Fungi →
